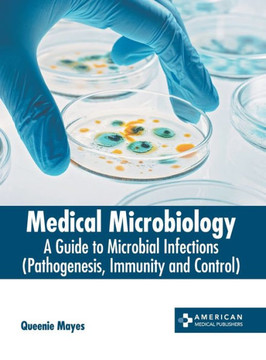

American Medical Publishers
Features mechanisms underlying viral immune evasion
Explores viroporins expressed by different families of viruses
Discusses the emerging importance of the innate immune mechanisms against Mycobacterium tuberculosis infection and latency
Author: Uday Kishore |
Publisher: Springer |
Publication Date: Dec 04, 2013 |
Number of Pages: 305 pages |
Binding: Hardback or Cased Book |
ISBN-10: 1461495296 |
ISBN-13: 9781461495291 |